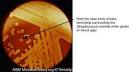
Estrectococo.jpeg

Estreptococos del grupo B
Estreptococo del grupo B: Es un tipo de bacteria determinado (germen) que habita las áreas vaginal o rectal de, aproximadamente, el 25% de las mujeres embarazadas sanas. Se dice que una mujer que tiene estreptococo del grupo B está "colonizada" por este germen. Si usted está colonizada con el estreptococo del grupo B, su bebé puede contraer la infección por estos gérmenes durante el parto y enfermarse. Las probabilidades de que esto suceda son menores al 1%, pero dado que la infección por estreptococo del grupo B es muy peligrosa para los bebés, es importante determinar si usted está colonizada durante su embarazo.
Sumario
Resumen
La infección perinatal por Estreptococo Grupo B (EGB) es la causa infecciosa más frecuente de mortalidad en este período de vida, ocasionando además morbilidad grave, y, con frecuencia, secuelas neurológicas de por vida; ello además del grave costo social y económico que significa. En este capítulo intentaremos conceptualizar los principales elementos epidemiológicos, bacteriológicos y fisiopatológicos de esta enfermedad, para finalmente establecer la normativa de manejo en nuestra Unidad. El EGB produce dos cuadros infecciosos graves en el recién nacido: enfermedad de comienzo precoz y enfermedad de comienzo tardío. La primera de ellas tiene una incidencia de 1-4 por 1000 RN vivos; es adquirida por transmisión vertical de madres colonizadas y puede ocurrir in útero o en los primeros 7 días de vida, habitualmente en las primeras horas; clínicamente se caracteriza por óbito fetal, neumonia, shock séptico y muerte neonatal con tasa de 10-20%. La enfermedad de comienzo tardío es de menor frecuencia, menos de la mitad de las veces es secundaria a transmisión vertical, se presenta entre la primera semana y los cuatro meses de vida, y su manifestación clínica habitual es una meningitis; de los sobrevivientes, aproximadamente el 50% permanecerá con secuelas neurológicas. La enfermedad de comienzo precoz es prevenible en gran medida durante el control prenatal, y es la preocupación fundamental de esta norma.
Bacteriología
Los estreptococos son gérmenes Gram positivos y se clasifican en Grupos (A, B, C, etc.) en base a carbohidratos específicos de su pared celular. El EGB posee además antígenos polisacáridos específicos que permiten su clasificación en cinco serotipos: Ia, Ib, Ic, II y III. Todos ellos se encuentran con igual frecuencia en mujeres embarazadas y son agentes etiológicos de la enfermedad descrita. Debemos recordar que los estreptococos poseen en su pared enzimas hemolíticas tales que, al ser cultivados en placas de agar sangre, permiten su clasificación en alfa, beta o no-hemolíticos; el estreptococo grupo A y el B, son del tipo beta hemolíticos; por lo tanto Estreptococo Grupo B y beta hemolítico, no son sinónimos. Para la detección de la colonización por EGB del tracto génitourinario, la técnica estándar es el cultivo, para lo cual debe usarse un medio selectivo, el que incluye antibióticos que inhiben el crecimiento de otras bacterias. Si bien las pruebas rápidas de detección inmunológica del EGB (latex, ELISA) son altamente específicos, poseen una sensibilidad que oscila entre el 60 y el 88%, por lo que su utilidad mayor está en la detección de portadoras altamente colonizadas. Así mismo, la tinción de Gram no es considerada una herramienta adecuada para el diagnóstico, pues posee una sensibilidad descrita de entre 30-80% con especificidad de sólo 60-70%. El EGB es particularmente sensible a la penicilina, siendo también sensible a las cefalosporinas, eritromicina y clindamicina. Es resistente a las sulfas, la tetraciclina y el metronidazol. La penicilina administrada a la madre por vía endovenosa puede ser encontrada en niveles terapéuticos en líquido amniótico y sangre de cordón, una hora después de la infusión. Si es administrada menos de una hora anteparto, no inhibe la colonización del RN. La eritromicina no cruza la placenta tan efectivamente como la penicilina. Por costo y efectividad, el antibiótico de elección es la Penicilina o Ampicilina endovenosa, reconociendo el riesgo de 1 en 100 de reacciones alérgicas leves y de 1 en 10.000 de anafilaxia grave.
Epidemiología
El EBG coloniza el tracto digestivo inferior del 15-35% de los humanos, siendo encontrado en hombres y mujeres de todas las edades. Desde allí la bacteria coloniza intermitentemente el tracto genital, y, menos frecuentemente, el tracto génitourinario Por ello cualquier protocolo que intente la detección del estado de portador, debe incluir el cultivo anorrectal; como ejemplo, en un estudio comparativo del sitio de colonización, el EGB fue encontrado: en el cuello 6%, en la vagina 8% y en ampolla rectal 11% de las embarazadas estudiadas. La colonización vaginal es intermitente, mientras que la colonización anorrectal es constante. No debe sostenerse por tanto que la colonización es intermitente en las embarazadas. Aproximadamente un 20% de las pacientes con cultivo vaginal negativo en el segundo trimestre, tendrán cultivo positivo al término, cifra que disminuye al 7,5-10% si se combina cultivo vaginal y anorrectal. Por el contrario, de las pacientes con cultivo vaginal positivo en la mitad del embarazo, el 30% será negativo al momento del parto. La incidencia de colonización vaginal por EGB tiene una marcada variación étnica y geográfica, estimándose que afecta al 15-40% de las embarazadas. En población norteamericana, por ejemplo, fue encontrado en el 13,7% de los cultivos vaginales en población blanca, 21,2% en las afroamericanas y 20% en las hispánicas. En Chile, la incidencia de positividad en cultivos vaginales publicada es aproximadamente 3,5 - 6%. La colonización sería mayor en mujeres con múltiples parejas sexuales y en las con menor nivel educacional, no existiendo relación con la edad, paridad u otras infecciones bacterianas vaginales. El 70% de los niños de madres colonizadas estarán colonizados al momento del nacimiento con el mismo serotipo que la madre; sin embargo, sólo 1-2% de ellos desarrollará infección por EGB.
Fisiopatología
El EGB llegaría a la cavidad amniótica luego de la rotura de las membranas. Sin embargo, hoy se sabe que también es capaz de infectar al feto con membranas indemnes; experimentalmente se ha demostrado su capacidad de adherirse, traspasar e incluso dividirse en la membrana amniótica. El concepto actual es que la mayoría de las infecciones perinatales por este germen son adquiridas in útero, siendo menos común la transmisión al momento del parto. Desde el líquido amniótico el EGB ingresa al tracto digestivo y respiratorio, donde genera potentes toxinas responsables de la enfermedad. Ellas son capaces de destruir el parénquima pulmonar, producir depresión miocárdica, espasmo de la vasculatura pulmonar, hipertensión pulmonar y shock. El organismo responde con activación del sistema inmune y liberación de mediadores inflamatorios que amplían la destrucción tisular y generan un aumento de la permeabilidad vascular, resultando en colapso circulatorio. El EGB puede, además, ser causa de muerte fetal en el segundo trimestre; en la anatomía patológica de esos casos se encuentra una neumonia por estreptococo. La investigación de esta etiología por histología y cultivos es parte fundamental del estudio del óbito de causa no explicada. Este cuadro clínico se asocia a embarazadas altamente colonizadas o con déficit de la inmunidad contra este germen.
Medios de contagio
¿Cómo puede contagiarse el GBS? La bacteria GBS vive en los intestinos y en las vías urinarias y genitales. Vive en forma natural en el cuerpo. Como adulto, no es posible contagiársela de los alimentos, agua o cosas que toca. Tampoco se la puede contagiar de otra persona ni por tener relaciones sexuales. ¿Cómo sabe si tiene el GBS? El profesional de la salud le hace una prueba para detectar el GBS entre las 35 y 37 semanas de embarazo. La prueba del GBS es sencilla e indolora. Se le toma una muestra de la vagina y el recto, y se la envía a un laboratorio. Los resultados de la prueba por lo general están listos en 1 ó 2 días. Su profesional de la salud también puede realizar pruebas rápidas de detección durante el parto para ver si tiene GBS. Pero esas pruebas no deberían reemplazar la prueba normal del GBS que se le hace entre las semanas 35 y 37 de embarazo. ¿Cómo puede proteger a su bebé contra el GBS? Si la prueba del GBS que se le hace entre las semanas 35 y 37 muestra que tiene la infección, el profesional le dará un medicamento llamado “antibiótico” durante el parto por vía intravenosa (por aguja en la vena). También es posible que se la trate si tiene algunos de los factores de riesgo del GBS y si no sabe los resultados de la prueba del GBS o no se le hizo la prueba todavía. El tratamiento con antibióticos ayuda a evitar que su bebé se contagie la infección. El mejor antibiótico para la mayoría de las mujeres es la penicilina. También puede usarse otro antibiótico llamado ampicilina. Esos medicamentos por lo general son seguros para usted y su bebé. Pero algunas mujeres (hasta 1 de cada 25 o el 4 por ciento) tratadas con penicilina tienen una reacción alérgica leve, como un sarpullido. Alrededor de 1 de cada 10.000 mujeres sufre una reacción alérgica grave que debe ser tratada de inmediato. Si es alérgica a la penicilina, su profesional de la salud puede tratarla con un medicamento distinto. Si la prueba muestra que tiene el GBS, recuérdeselo a los profesionales de la salud del hospital cuando vaya a tener a su bebé. De esa forma, se la puede tratar rápidamente. El tratamiento surte mejor efecto cuando comienza al menos 4 horas antes del parto. Si tiene el GBS y se le va a hacer una cesárea programada antes de que comience el trabajo de parto y antes de que se le rompa la fuente de agua, es probable que no necesite antibióticos. No surte efecto tomar antibióticos orales antes del parto para tratar el GBS. La bacteria puede regresar rápidamente, y podría volver a tenerla para el momento en que está naciendo el bebé.
Factores de riesgos
- Pacientes sin factores de riesgo:
- No requieren cultivos de screening - Si inicia trabajo de parto prematuro, o presenta rotura prematura de membranas de pretérmino: manejo según norma respectiva - Si se efectúa diagnóstico de infección ovular intraparto: manejo según norma respectiva (ver "Rotura Prematura de Membranas") - Se recomienda tratamiento antibiótico e.v., con el esquema propuesto, en partos de tepresenta como único hallazgo fiebre intraparto mayor a 38ºC -y/o membranas rotas por más de 18 horas:
- Pacientes con factores de riesgo para infección por EGB:
- Antecedente RN previo con sepsis por EGB - Antecedente de parto prematuro idiopático o por rotura prematura de membranas - Bacteriuria por EGB en este embarazo - Administrar tratamiento antibiótico intraparto con el siguiente esquema: - Ampicilina e.v. 2 g e.v carga y luego 1 g c/4 h hasta el parto en alérgicas a PNC usar Clindamicina e.v. 900 mg e. v. c/8 h hasta el parto
Prevención
El recibir antibióticos durante el parto no previene la aparición tardía de esta enfermedad. De hecho, sólo la mitad de los bebés que se contagian de forma tardía tienen madres portadoras del estreptococo del grupo B; nadie sabe cómo el resto se contagia de la bacteria. Los investigadores están trabajando en una vacuna contra el estreptococo del grupo B que esperan elimine la enfermedad de aparición temprana y también la de aparición tardía, junto con la necesidad de pruebas y tratamiento. También podrá prevenir los casos poco comunes de partos de bebés que nacen sin vida y nacimientos prematuros relacionados con el estreptococo del grupo B.
Fuentes
- http://www.escuela.med.puc.cl/paginas/departamentos/obstetricia/.../estreptococo.htm
- http://www.nacersano.org/centro/9254_9656.asp
- http://www.nlm.nih.gov/medlineplus/spanish/ency/.../000511.htm
- http://espanol.babycenter.com/a900766/prueba-del-estreptococo-del-grupo-b-durante-el-embarazo#ixzz2WVPbSP8l